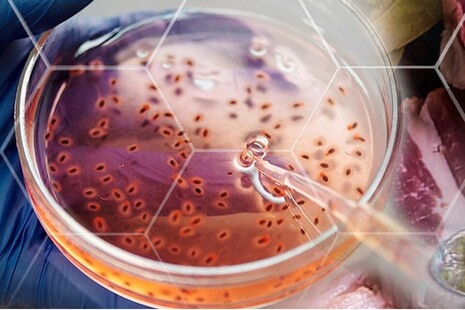
Cells in pipette plate

Government Chemist
Featured
Corporate report
Government Chemist Review 2024
Referee casework, research projects, advice and impact of work carried out by the Government Chemist team during 2024.

News story
Guidelines for the characterisation of microplastics with LD-IR
A guide for testing laboratories on the application of Laser Direct Infrared (LD-IR) for the microplastics characterisation

News story
Government Chemist Conference 2026 - save the date
The Government Chemist Conference will take place on 23-24 June 2026 at Nexus, University of Leeds with remote attendance options

News story
E-seminar: Verification of frozen poultry via HADH
An e-seminar produced as part of the Joint Knowledge Transfer Framework for Food Standards and Food Safety Analysis

Research and analysis
Quantitative review of sustainable novel food production
Evaluation of alternative protein sources to support UK Net Zero targets, reduce food system greenhouse gases, and drive sustainable innovation.
Corporate report
Government Chemist Review 2023
Referee casework, research projects, advice and impact of work carried out by the Government Chemist team during 2023

Latest from Government Chemist
What we do
We resolve scientific disputes mainly in the food and feed sectors, give advice to regulators and industry, and carry out research.
Government Chemist is part of the Department for Science, Innovation and Technology.
Follow us
Documents
Transparency and freedom of information releases
Our management






Contact Government Chemist
Government Chemist
10 Priestley Road
Guildford
Surrey
GU27XY
United Kingdom
Make an FOI request
- Read about the Freedom of Information (FOI) Act and how to make a request.
- Check our previous releases to see if we’ve already answered your question.
Corporate information
Our Personal information charter explains how we treat your personal information.